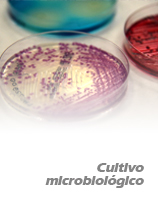
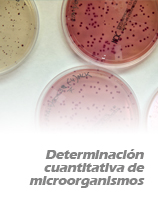
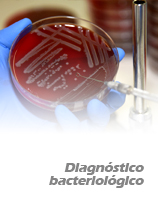
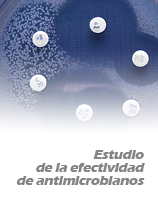

Análisis de laboratorio

|

|

|
|
|
|

|
|

|

|

|

|
Referencia: A715
Biopsia
Procesado de tejidos y tinción histológica para estudio de secciones fijadas en Formaldehído y embebidas en parafina (FFPE). Informe de hallazgos microscópicos incluido.
@


| ● | Biopsia |
Referencia: A753
Estudio histoquímico e inmunohistoquímico de Tuberculosis bovina
Estudio mediante las técnicas de hematoxilina-eosina, Ziehl-Nielssen y técnica de inmunohistoquímica
ISO


| ● | Estudio histoquímico e inmunohistoquímico de Tuberculosis bovina |
Referencia: A723
Examen citológico en muestras biológicas animales
Tinción y estudio de muestras biológicas (sangre, líquido sinovial, etc) (Informe incluido)
@


| ● | Examen citológico en muestras biológicas animales |
Referencia: A717
Necropsia acuicultura por pez sin incluir pruebas complementarias
Necropsia de productos de acuicultura. Informe de los hallazgos macroscópicos encontrados. Incluye toma de muestras, estudio de parásitos branquiales en fresco, procesado de téjidos y tinción histológica para estudio de secciones fijadas en formaldehído embebidas en parafina. Pruebas complementarias no incluidas (microbiología, virología, toxicología), requieren de presupuesto por separado.
@


| ● | Necropsia acuicultura por pez sin incluir pruebas complementarias |
Referencia: A725
Necropsia animal de animales de tamaño grande (hasta 100kg)
Necropsia animal de tamaño grande e informe de los hallazgos macroscópicos encontrados. Incluye toma de muestras, procesado de téjidos y tinción histológica para estudio de secciones fijadas en formaldehído embebidas en parafina. Pruebas complementarias no incluidas (microbiología, virología, toxicología), requieren de presupuesto por separado.
@


| ● | Necropsia animal de animales de tamaño grande (hasta 100kg) |
Referencia: A716
Necropsia animal de animales de tamaño mediano
Necropsia animal de tamaño mediano e informe de los hallazgos macroscópicos encontrados. Incluye toma de muestras, procesado de téjidos y tinción histológica para estudio de secciones fijadas en formaldehído embebidas en parafina. Pruebas complementarias no incluidas (microbiología, virología, toxicología), requieren de presupuesto por separado.
@


| ● | Necropsia animal de animales de tamaño mediano |
Referencia: A747
Necropsia animal de animales de tamaño pequeño/laboratorio
Necropsia animal de tamaño pequeño e informe de los hallazgos macroscópicos encontrados. Incluye toma de muestras, procesado de téjidos y tinción histológica para estudio de secciones fijadas en formaldehído embebidas en parafina. Pruebas complementarias no incluidas (microbiología, virología, toxicología), requieren de presupuesto por separado.
@


| ● | Necropsia animal de animales de tamaño pequeño/laboratorio |
Referencia: A752
Necropsia con sospecha de Rabia/agente infeccioso BSL-3
Estudio macroscópico e histopatológico procedente de animales con sospecha de algún agente infeccioso de Nivel de Bioseguridad 3, especialmente Rabía con extracción de encefalo y envío a laboratorio de referencia.
| ● | Necropsia con sospecha de Rabia/agente infeccioso BSL-3 |
Referencia: A729
Necropsia Forense Veterinaria
Necropsia forense animal, toma de muestras, procesado de tejidos y tinción histológica (según requerimiento) para estudio de secciones fijadas en Formaldehído y embebidas en parafina (FFPE). Informe de hallazgos incluido. Pruebas complementarias no incluidas (microbiología, virología, toxicología), requieren de presupuesto por separado.
@


| ● | Necropsia Forense Veterinaria |
Referencia: A756
Técnica inmunohistoquímica (con Anticuerpo de Servicio SAP)
Reacción antígeno-anticuerpo específica para la detección de distintos agentes infecciosos y componentes procedentes de tumores, mediante la aplicación de inmunoteñidor con unidad PT.
| ● | Técnica inmunohistoquímica (con Anticuerpo de Servicio SAP) |
Referencia: A755
Técnica inmunohistoquímica (con aportación de Anticuerpo por parte del solicitante)
Reacción antígeno-anticuerpo específica para la detección de distintos agentes infecciosos y componentes procedentes de tumores, mediante la aplicación de inmunoteñidor con unidad PT.
| ● | Técnica inmunohistoquímica (con aportación de Anticuerpo por parte del solicitante) |
Referencia: A754
Técnicas histoquímicas específicas
Técnicas complementarias para el estudio de componentes específicos a nivel tisular. Tricrómico, PAS, May Grünwald Giemsa, etc.
| ● | Técnicas histoquímicas específicas |
Referencia: A457
Biotipado de Yersinia enterocolitica
Biotipado de Yersinia enterocolitica mediante pruebas bioquímicas
| ● | Biotipado de Yersinia enterocolitica |
Referencia: A476
Caracterización de serotipo 1, 2, 7 o 9 de Streptococcus suis mediante PCR
Caracterización de serotipado de Streptococcus suis mediante PCR. El coste del análisis conrrepsonde a la determinación de cada serotipo.
| ● | Caracterización de serotipo 1, 2, 7 o 9 de Streptococcus suis mediante PCR |
Referencia: A471
Caracterización del tipo capsular de Pasteurella multocida mediante PCR
Caracterización del tipo capsular (A, B, D, E o F) de Pasteurella multocida mediante PCR. El coste del análisis se corresponde con cada tipo capsular
| ● | Caracterización del tipo capsular de Pasteurella multocida mediante PCR |
Referencia: A461
Confirmación de variante monofásica de Salmonella Typhimurium
Confirmación de variante monofásica de Salmonella Typhimurium mediante PCR convencional
| ● | Confirmación de variante monofásica de Salmonella Typhimurium |
Referencia: A458
Confirmación del serotipo O:3 de Yersinia enterocolitica
Confirmación del serotipo O:3 de Yersinia enterocolitica mediante técnicas serológicas
| ● | Confirmación del serotipo O:3 de Yersinia enterocolitica |
Referencia: A582
Confirmación del serotipo O:9 de Yersinia enterocolitica
Confirmación del serotipo O:9 de Yersinia enterocolitica mediante técnicas serológicas
| ● | Confirmación del serotipo O:9 de Yersinia enterocolitica |
Referencia: A496
Determinación del serotipo de Escherichia coli en base a técnicas fenotípicas.
Determinación del serotipo de Escherichia coli en base a técnicas fenotípicas. El coste del análisis dependerá del número de monovalentes empleados
| ● | Determinación del serotipo de Escherichia coli en base a técnicas fenotípicas. |
Referencia: A445
Identificación de Salmonella enterica subespecie enterica mediante serotipado
Serotipado de colonias de Salmonella enterica subspecie enterica según el esquema de Kauffman-White
ISO


| ● | Identificación de Salmonella enterica subespecie enterica mediante serotipado |
Referencia: A685
Caracterización de Staphylococcus aureus mediante MLST
Tipificación de S. aureus mediante la secuenciación de genes conservados (MLST)
| ● | Caracterización de Staphylococcus aureus mediante MLST |
Referencia: A684
Caracterización de Staphylococcus aureus mediante spa typing
Secuenciación de la fracción variable del gen spa en aislados de S. aureus
| ● | Caracterización de Staphylococcus aureus mediante spa typing |
Referencia: A520
Caracterización molecular de Aerococcus viridans mediante la electroforesis de campo pulsado (PFGE).
Caracterización de Aerococcus viridans mediante la electroforesis de campo pulsado (PFGE). El coste de los análisis dependerá del número de enzimas empleadas.
| ● | Caracterización molecular de Aerococcus viridans mediante la electroforesis de campo pulsado (PFGE). |
Referencia: A491
Caracterización molecular de Aeromonas salmonicida mediante electroforesis de campo pulsado (PFGE)
Caracterización molecular de Aeromonas salmonicida mediante electroforesis de campo pulsado (PFGE). El coste de los análisis dependerá del número de enzimas empleadas
| ● | Caracterización molecular de Aeromonas salmonicida mediante electroforesis de campo pulsado (PFGE) |
Referencia: A506
Caracterización molecular de Clostridium perfringens mediante la electroforesis de campo pulsado (PFGE).
Caracterización molecular de Clostridium perfringens mediante la electroforesis de campo pulsado (PFGE). El coste de los análisis dependerá del número de enzimas empleadas
| ● | Caracterización molecular de Clostridium perfringens mediante la electroforesis de campo pulsado (PFGE). |
Referencia: A507
Caracterización molecular de Clostridium sordellii mediante la electroforesis de campo pulsado (PFGE).
Caracterización molecular de Clostridium sordellii mediante la electroforesis de campo pulsado (PFGE).El coste de los análisis dependerá del número de enzimas empleadas
| ● | Caracterización molecular de Clostridium sordellii mediante la electroforesis de campo pulsado (PFGE). |
Referencia: A536
Caracterización molecular de Enterococcus hyrae mediante la electroforesis de campo pulsado (PFGE).
Caracterización molecular de Enterococcus hyrae mediante la electroforesis de campo pulsado (PFGE).El coste de los análisis dependerá del número de enzimas empleadas
| ● | Caracterización molecular de Enterococcus hyrae mediante la electroforesis de campo pulsado (PFGE). |
Referencia: A486
Caracterización molecular de Erysipelothrix spp. mediante electroforesis de campo pulsado (PFGE)
Caracterización molecular de Erysipelothrix spp. mediante electroforesis de campo pulsado (PFGE).El coste de los análisis dependerá del número de enzimas empleadas
| ● | Caracterización molecular de Erysipelothrix spp. mediante electroforesis de campo pulsado (PFGE) |
Referencia: A497
Caracterización molecular de Escherichia coli mediante la electroforesis de campo pulsado (PFGE).
Caracterización molecular de Escherichia coli mediante la electroforesis de campo pulsado (PFGE). El coste de los análisis dependerá del número de enzimas empleadas
| ● | Caracterización molecular de Escherichia coli mediante la electroforesis de campo pulsado (PFGE). |
Referencia: A489
Caracterización molecular de Flavobacterias spp. mediante electroforesis de campo pulsado (PFGE)
Caracterización molecular de Flavobacterias spp. mediante electroforesis de campo pulsado (PFGE). El coste de los análisis dependerá del número de enzimas empleadas
| ● | Caracterización molecular de Flavobacterias spp. mediante electroforesis de campo pulsado (PFGE) |
Referencia: A482
Caracterización molecular de Haemophilus parasuis mediante electroforesis de campo pulsado (PFGE)
Caracterización molecular de Haemophilus parasuis mediante electroforesis de campo pulsado (PFGE). El coste de los análisis dependerá del número de enzimas empleadas
| ● | Caracterización molecular de Haemophilus parasuis mediante electroforesis de campo pulsado (PFGE) |
Referencia: A493
Caracterización molecular de Lactococcus garvieae mediante electroforesis de campo pulsado (PFGE)
Caracterización molecular de Lactococcus garvieae mediante electroforesis de campo pulsado (PFGE). El coste de los análisis dependerá del número de enzimas empleadas
| ● | Caracterización molecular de Lactococcus garvieae mediante electroforesis de campo pulsado (PFGE) |
Referencia: A526
Caracterización molecular de Listeria monocytogenes mediante la electroforesis de campo pulsado (PFGE).
Caracterización molecular de Listeria monocytogenes mediante la electroforesis de campo pulsado (PFGE). El coste de los análisis dependerá del número de enzimas empleadas
| ● | Caracterización molecular de Listeria monocytogenes mediante la electroforesis de campo pulsado (PFGE). |
Referencia: A694
Caracterización molecular de micobacterias pertenecientes al complejo Mycobacterium tuberculosis mediante Direct Variable Repeat spacer oligonucleotide typing (DVR-spoligotyping)
La técnica de Direct Variable Repeat spacer oligonucleotide typing o DVR-spoligotyping se basa en la amplificación de los espaciadores entre las secuencias DR (direct repeat) mediante una reacción en cadena de la polimerasa (PCR). Posteriormente los espaciadores son detectados mediante hibridación de los productos generados por PCR a una membrana que contiene 43 oligonucleótidos unidos covalentemente. Al final del protocolo se obtiene un patrón, denominado perfil de espoligo o espoligotipo, que se caracteriza por la presencia o ausencia de espaciadores.
ISO


| ● | Caracterización molecular de micobacterias pertenecientes al complejo Mycobacterium tuberculosis mediante Direct Variable Repeat spacer oligonucleotide typing (DVR-spoligotyping) |
Referencia: A695
Caracterización molecular de micobacterias pertenecientes al complejo Mycobacterium tuberculosis mediante VNTR
| ● | Caracterización molecular de micobacterias pertenecientes al complejo Mycobacterium tuberculosis mediante VNTR |
Referencia: A472
Caracterización molecular de Pasteurella multocida mediante electroforesis de campo pulsado (PFGE)
Caracterización molecular de Pasteurella multocida mediante electroforesis de campo pulsado (PFGE. El coste de los análisis dependerá del número de enzimas empleadas
| ● | Caracterización molecular de Pasteurella multocida mediante electroforesis de campo pulsado (PFGE) |
Referencia: A487
Caracterización molecular de Pseudomonas angilliseptica mediante electroforesis de campo pulsado (PFGE)
Caracterización molecular de Pseudomonas angilliseptica mediante electroforesis de campo pulsado (PFGE). El coste de los análisis dependerá del número de enzimas empleadas
| ● | Caracterización molecular de Pseudomonas angilliseptica mediante electroforesis de campo pulsado (PFGE) |
Referencia: A533
Caracterización molecular de Staphylococcus epidermidis mediante la electroforesis de campo pulsado (PFGE).
Caracterización molecular de Staphylococcus epidermidis mediante la electroforesis de campo pulsado (PFGE). El coste de los análisis dependerá del número de enzimas empleadas
| ● | Caracterización molecular de Staphylococcus epidermidis mediante la electroforesis de campo pulsado (PFGE). |
Referencia: A527
Caracterización molecular de Streptococcus dysgalactiae mediante la electroforesis de campo pulsado (PFGE).
Caracterización molecular de Streptococcus dysgalactiae mediante la electroforesis de campo pulsado (PFGE).El coste de los análisis dependerá del número de enzimas empleadas
| ● | Caracterización molecular de Streptococcus dysgalactiae mediante la electroforesis de campo pulsado (PFGE). |
Referencia: A538
Caracterización molecular de Streptococcus equi subsp. zooepidemicus mediante electroforesis de campo pulsado (PFGE).
Caracterización molecular de Streptococcus equi subsp. zooepidemicus mediante electroforesis de campo pulsado (PFGE). El coste de los análisis dependerá del número de enzimas empleadas.
| ● | Caracterización molecular de Streptococcus equi subsp. zooepidemicus mediante electroforesis de campo pulsado (PFGE). |
Referencia: A539
Caracterización molecular de Streptococcus pyogenes mediante electroforesis de campo pulsado (PFGE).
Caracterización molecular de Streptococcus pyogenes mediante electroforesis de campo pulsado (PFGE).El coste de los análisis dependerá del número de enzimas empleadas
| ● | Caracterización molecular de Streptococcus pyogenes mediante electroforesis de campo pulsado (PFGE). |
Referencia: A477
Caracterización molecular de Streptococcus suis mediante electroforesis de campo pulsado (PFGE)
Caracterización molecular de Streptococcus suis mediante electroforesis de campo pulsado (PFGE). El coste de los análisis dependerá del número de enzimas empleadas
| ● | Caracterización molecular de Streptococcus suis mediante electroforesis de campo pulsado (PFGE) |
Referencia: A488
Caracterización molecular de Vibrio spp. mediante electroforesis de campo pulsado (PFGE)
Caracterización molecular de Vibrio spp. mediante electroforesis de campo pulsado (PFGE).El coste de los análisis dependerá del número de enzimas empleadas
| ● | Caracterización molecular de Vibrio spp. mediante electroforesis de campo pulsado (PFGE) |
Referencia: A494
Caracterización molecular de Yersinia ruckeri mediante electroforesis de campo pulsado (PFGE).
Caracterización molecular de Yersinia ruckeri mediante electroforesis de campo pulsado (PFGE).El coste de los análisis dependerá del número de enzimas empleadas
| ● | Caracterización molecular de Yersinia ruckeri mediante electroforesis de campo pulsado (PFGE). |
Referencia: A549
Cultivo microbiológico a partir de muestras clínicas en medios específicos para Brucella
Cultivo microbiológico a partir de muestras clínicas en medios específicos para Brucella. Se realiza dentro de las instalaciones de nivel 3
| ● | Cultivo microbiológico a partir de muestras clínicas en medios específicos para Brucella |
Referencia: A555
Cultivo microbiológico a partir de muestras clínicas en medios específicos para Francisella
Cultivo microbiológico a partir de muestras clínicas en medios específicos para Francisella
| ● | Cultivo microbiológico a partir de muestras clínicas en medios específicos para Francisella |
Referencia: A683
Detección de Campylobacter termotolerante en alimentos
Detección de Campylobacter termotolerante en muestras de alimentos basado en ISO 10272
| ● | Detección de Campylobacter termotolerante en alimentos |
Referencia: A459
Detección de Campylobacter termotolerante en heces
Detección de Campylobacter termotolerante en heces basado en ISO 10272
| ● | Detección de Campylobacter termotolerante en heces |
Referencia: A573
Detección de Escherichia coli indicador
Aislamiento de Escherichia coli indicador mediante cultivo microbiológico
| ● | Detección de Escherichia coli indicador |
Referencia: A456
Detección de Escherichia coli O157:H7 en alimentos
Aislamiento de Escherichia coli O157:H7 según ISO 16654:2001
| ● | Detección de Escherichia coli O157:H7 en alimentos |
Referencia: A460
Detección de Escherichia coli presuntivo de producir betalactamasas (BLEAs/AmpC) en carne
Detección de Escherichia coli presuntivo de producir betalactamasas (BLEAs/AmpC) en carne basado en el protocolo del EURL-AR
ISO


| ● | Detección de Escherichia coli presuntivo de producir betalactamasas (BLEAs/AmpC) en carne |
Referencia: A749
Detección de Escherichia coli presuntivo de producir betalactamasas (BLEAs/AmpC) en muestras de heces
Detección de Escherichia coli presuntivo de producir betalactamasas (BLEAs/AmpC) en muestras de heces basado en el protocolo del EURL-AR
| ● | Detección de Escherichia coli presuntivo de producir betalactamasas (BLEAs/AmpC) en muestras de heces |
Referencia: A575
Detección de Escherichia coli presuntivo de producir carbapenemasas/OXA-48 en carne
Detección de Escherichia coli presuntivo productor de carbapenemasas/OXA-48 basado en el protocolo del EURL-AR en carne
ISO


| ● | Detección de Escherichia coli presuntivo de producir carbapenemasas/OXA-48 en carne |
Referencia: A750
Detección de Escherichia coli presuntivo productor de carbapenemasas/OXA-48 en muestras de heces
Detección de Escherichia coli presuntivo productor de carbapenemasas/OXA-48 basado en el protocolo del EURL-AR en heces
| ● | Detección de Escherichia coli presuntivo productor de carbapenemasas/OXA-48 en muestras de heces |
Referencia: A462
Detección de Escherichia coli verotoxigénico
Detección de Escherichia coli verotoxigénico en muestras de origen animal
| ● | Detección de Escherichia coli verotoxigénico |
Referencia: A696
Detección de Mycobacterium spp. mediante técnicas de cultivo
Detección de Mycobacterium spp. mediante técnicas de cultivo
ISO


| ● | Detección de Mycobacterium spp. mediante técnicas de cultivo |
Referencia: A443
Detección de Salmonella spp. en heces
Aislamiento e identificación de Salmonella spp. en heces basado en la norma ISO 6579-1:2017/A1
ISO


| ● | Detección de Salmonella spp. en heces |
Referencia: A444
Detección de Salmonella spp. en productos de consumo humano o animal
Detección de Salmonella spp. en productos de consumo humano o animal basado en la norma ISO 6579-1:2017/A1
ISO


| ● | Detección de Salmonella spp. en productos de consumo humano o animal |
Referencia: A455
Detección de Staphylococcus aureus resistentes a meticilina (SARM)
Aislamiento e identificación de Staphylococcus aureus resistentes a meticilina (SARM)
| ● | Detección de Staphylococcus aureus resistentes a meticilina (SARM) |
Referencia: A454
Detección de Yersinia enterocolitica
Detección de Yersinia enterocolitica mediante cultivo tradicional
| ● | Detección de Yersinia enterocolitica |
Referencia: A449
Recuento de aerobios mesófilos
Recuento en agar para el recuento en placa (PCA) según ISO 4833:2003
| ● | Recuento de aerobios mesófilos |
Referencia: A451
Recuento de anaerobios mesófilos
Recuento de mesófilos anaerobios en agar PCA
| ● | Recuento de anaerobios mesófilos |
Referencia: A580
Recuento de Clostridium perfringens
Recuento en medio selectivo agar Sulfito Polimixina Sulfadiazina (SPS) según ISO 7937:2004
| ● | Recuento de Clostridium perfringens |
Referencia: A453
Recuento de Enterobacterias
Recuento en medio selectivo agar bilis rojo violeta (VRBG) según ISO 21528-2:2004
| ● | Recuento de Enterobacterias |
Referencia: A448
Recuento de Escherichia coli
Recuento en medio selectivo Triptona-Bilis-X-Glucorónido (TBX) según ISO 16649-2:2001
| ● | Recuento de Escherichia coli |
Referencia: A450
Recuento de microorganismos sulfitorreductores en anaerobiosis
Recuento en medio selectivo agar sulfito de hierro según ISO 15213:2003
| ● | Recuento de microorganismos sulfitorreductores en anaerobiosis |
Referencia: A452
Recuento de Staphylococcus spp.
Recuento de Staphylococcus spp. en medio selectivo
| ● | Recuento de Staphylococcus spp. |
Referencia: A468
Diagnóstico bacteriológico de microorganismos implicados en procesos clínicos de peces
Diagnóstico bacteriológico de microorganismos implicados en procesos clínicos de peces
| ● | Diagnóstico bacteriológico de microorganismos implicados en procesos clínicos de peces |
Referencia: A466
Diagnóstico bacteriológico general
Diagnóstico bacteriológico general (bacterias aerobias, anaerobias y microaerófilas) a partir de muestras clínicas de origen animal. El coste dependerá del tipo de análisis solicitado.
| ● | Diagnóstico bacteriológico general |
Referencia: A618
Detección de anticuerpos frente a Babesia caballi en équidos mediante ELISA de competición
Análisis para la detección de anticuerpos frente a Babesia caballi en suero de équidos mediante ELISA de competición
| ● | Detección de anticuerpos frente a Babesia caballi en équidos mediante ELISA de competición |
Referencia: A550
Detección de anticuerpos frente a Brucella spp mediante ELISA
Detección de anticuerpos frente a Brucella spp mediante ELISA
| ● | Detección de anticuerpos frente a Brucella spp mediante ELISA |
Referencia: A612
Detección de anticuerpos frente a Brucella spp. mediante Rosa de Bengala
Análisis para la detección de anticuerpos frente a Brucella spp. en suero de équidos mediante Rosa de Bengala
@


| ● | Detección de anticuerpos frente a Brucella spp. mediante Rosa de Bengala |
Referencia: A615
Detección de anticuerpos frente a Burkholderia mallei (muermo equino) mediante fijación de complemento
Análisis para la detección de anticuerpos frente a Burkholderia mallei (muermo equino) en suero de équidos mediante fijación de complemento
@


| ● | Detección de anticuerpos frente a Burkholderia mallei (muermo equino) mediante fijación de complemento |
Referencia: A551
Detección de anticuerpos frente a Coxiella burnetii mediante ELISA
Detección de anticuerpos frente a Coxiella burnetii mediante ELISA
| ● | Detección de anticuerpos frente a Coxiella burnetii mediante ELISA |
Referencia: A626
Detección de anticuerpos frente a Herpesvirus equino tipo 1 y tipo 4 en équidos mediante Seroneutralización
Análisis para la detección de anticuerpos frente a Herpesvirus equino tipo 1 y tipo 4 en suero de équidos mediante Seroneutralización
| ● | Detección de anticuerpos frente a Herpesvirus equino tipo 1 y tipo 4 en équidos mediante Seroneutralización |
Referencia: A617
Detección de anticuerpos frente a Theileria equi mediante ELISA de competición
Análisis para la detección de anticuerpos frente a Theileria equi en suero de équidos mediante ELISA de competición
| ● | Detección de anticuerpos frente a Theileria equi mediante ELISA de competición |
Referencia: A619
Detección de anticuerpos frente a Theileria equi y Babesia caballi (Piroplasmosis Equina) mediante ELISA de competición
Análisis para la detección de anticuerpos frente a Theileria equi y Babesia caballi (piroplasmosis equina) en suero de équidos mediante ELISA de competición
@


| ● | Detección de anticuerpos frente a Theileria equi y Babesia caballi (Piroplasmosis Equina) mediante ELISA de competición |
Referencia: A693
Detección de anticuerpos frente a Toxoplasma gondii mediante ELISA
Detección de anticuerpos frente a T. gondii mediante ELISA
| ● | Detección de anticuerpos frente a Toxoplasma gondii mediante ELISA |
Referencia: A613
Detección de anticuerpos frente a Trypanosoma equiperdum (Durina Equina) mediante fijación de complemento
Análisis para la detección de anticuerpos frente a Trypanosoma equiperdum (Durina Equina) en suero de équidos mediante fijación de complemento
@


| ● | Detección de anticuerpos frente a Trypanosoma equiperdum (Durina Equina) mediante fijación de complemento |
Referencia: A609
Detección de anticuerpos frente al virus de Anemia Infecciosa Equina mediante Inmunodifusión en gel de agar (Test de Coggins)
Análisis para la detección de anticuerpos frente al virus de Anemia Infecciosa Equina en suero de équidos mediante Inmunodifusión en gel de agar (Test de Coggins), con lectura de resultados a 48 horas.
@


| ● | Detección de anticuerpos frente al virus de Anemia Infecciosa Equina mediante Inmunodifusión en gel de agar (Test de Coggins) |
Referencia: A610
Detección de anticuerpos frente al virus de Arteritis Vírica Equina mediante ELISA y confirmación de dudosos mediante Seroneutralización
Análisis para la detección de anticuerpos frente al virus de Arteritis Vírica Equina en suero de équidos mediante ELISA y confirmación de dudosos mediante Seroneutralización
@


| ● | Detección de anticuerpos frente al virus de Arteritis Vírica Equina mediante ELISA y confirmación de dudosos mediante Seroneutralización |
Referencia: A545
Detección de anticuerpos frente al virus de la Influenza tipo A mediante ELISA
Detección de anticuerpos frente al virus de la Influenza tipo A mediante ELISA
| ● | Detección de anticuerpos frente al virus de la Influenza tipo A mediante ELISA |
Referencia: A547
Detección de anticuerpos frente al virus de Newcastle mediante ELISA
Detección de anticuerpos frente al virus de Newcastle mediante ELISA
| ● | Detección de anticuerpos frente al virus de Newcastle mediante ELISA |
Referencia: A614
Detección de anticuerpos tipo IgM frente a West Nile Virus previa exportación mediante ELISA de captura
Análisis para la detección de anticuerpos tipo IgM frente a West Nile Virus en suero de équidos previa exportación mediante ELISA de captura
@


| ● | Detección de anticuerpos tipo IgM frente a West Nile Virus previa exportación mediante ELISA de captura |
Referencia: A440
Diagnóstico de tuberculosis mediante la detección anticuerpos por ELISA
| ● | Diagnóstico de tuberculosis mediante la detección anticuerpos por ELISA |
Referencia: A698
Diagnóstico de tuberculosis mediante la técnica de detección del Gamma-Interferón in vitro por ELISA
ISO


| ● | Diagnóstico de tuberculosis mediante la técnica de detección del Gamma-Interferón in vitro por ELISA |
Referencia: A743
Pre-exportación: Piroplasmosis equina (cELISA + qPCR)
Detección de anticuerpos frente a Theileria equi y Babesia caballi (piroplasmosis equina) en suero de équidos mediante ELISA de competición + Detección de ADN de Theileria equi y Babesia caballi (Piroplasmosis equina) en muestras de équidos mediante qPCR a tiempo real.
@


∞


| ● | Pre-exportación: Piroplasmosis equina (cELISA + qPCR) |
Referencia: A744
Pre-exportación: Piroplasmosis equina (cELISA + qPCR) + Anemia infecciosa equina (Test de Coggins) + Muermo (FC) + Durina (FC)
Detección de anticuerpos frente a Piroplasmosis Equina mediante ELISA de competición + Detección de ADN de Theileria equi y Babesia caballi (Piroplasmosis equina) en muestras de équidos mediante qPCR a tiempo real + Detección de anticuerpos frente al virus de Anemia Infecciosa Equina mediante Test de Coggins + Detección de anticuerpos frente a Burkholderia mallei (Muermo Equino) mediante Fijación de Complemento + Detección de anticuerpos frente a Trypanosoma equiperdum (Durina Equina) mediante Fijación de Complemento. Análisis informativo para exportación a EEUU.
@


∞


| ● | Pre-exportación: Piroplasmosis equina (cELISA + qPCR) + Anemia infecciosa equina (Test de Coggins) + Muermo (FC) + Durina (FC) |
Referencia: A699
Prueba de la intradermotuberculinización
Test de intradermotuberculinización
ISO


| ● | Prueba de la intradermotuberculinización |
Referencia: A745
Reproductores: Taylorella equigenitalis (Metritis Contagiosa Equina) mediante PCR a tiempo real + Arteritis Vírica Equina (ELISA +/ SN)
Detección de ADN de Taylorella equigenitalis (Metritis Contagiosa Equina) mediante PCR a tiempo real en hisopo genital de équidos + detección de anticuerpos frente a Arteritis Vírica Equina mediante ELISA y confirmación de dudosos mediante Seroneutralización.
@


∞


| ● | Reproductores: Taylorella equigenitalis (Metritis Contagiosa Equina) mediante PCR a tiempo real + Arteritis Vírica Equina (ELISA +/ SN) |
Referencia: A746
Reproductores: Taylorella equigenitalis (Metritis Contagiosa Equina) mediante PCR a tiempo real + Arteritis Vírica Equina (ELISA +/ SN) + Anemia Infecciosa Equina (Test de Coggins)
Detección de ADN de Taylorella equigenitalis (Metritis Contagiosa Equina) mediante PCR a tiempo real en hisopo genital de équidos + detección de anticuerpos frente a Arteritis Vírica Equina mediante ELISA y confirmación de dudosos mediante Seroneutralización + detección de anticuerpos frente a Anemia Infecciosa Equina mediante Test de Coggins.
@


∞


| ● | Reproductores: Taylorella equigenitalis (Metritis Contagiosa Equina) mediante PCR a tiempo real + Arteritis Vírica Equina (ELISA +/ SN) + Anemia Infecciosa Equina (Test de Coggins) |
Referencia: A734
Serología: Anemia Infecciosa Equina (Test de Coggins) + Muermo (FC) + Durina (FC)
Detección de anticuerpos frente al virus de Anemia Infecciosa Equina mediante Test de Coggins + Detección de anticuerpos frente a Burkholderia mallei (Muermo Equino) mediante Fijación de Complemento + Detección de anticuerpos frente a Trypanosoma equiperdum (Durina Equina) mediante Fijación de Complemento.
Análisis informativo para exportación a Arabia Saudí, Bahrein, Emiratos Árabes, Jordania, Líbano, Marruecos, Quatar.
@


| ● | Serología: Anemia Infecciosa Equina (Test de Coggins) + Muermo (FC) + Durina (FC) |
Referencia: A735
Serología: Arteritis Vírica Equina (ELISA +/ SN) + Brucella (Rosa de Bengala) + Anemia Infecciosa Equina (Test de Coggins)
Detección de anticuerpos frente al virus de Arteritis Vírica Equina mediante ELISA y confirmación de dudosos mediante Seroneutralización + Detección de anticuerpos frente a Brucella spp. mediante Rosa de Bengala + Detección de anticuerpos frente al virus de Anemia Infecciosa Equina mediante Test de Coggins.
Análisis informativo para exportación a Guatemala.
| ● | Serología: Arteritis Vírica Equina (ELISA +/ SN) + Brucella (Rosa de Bengala) + Anemia Infecciosa Equina (Test de Coggins) |
Referencia: A730
Serología: Arteritis Vírica Equina (ELISA +/ SN) + Piroplasmosis Equina (cELISA)
Detección de anticuerpos frente al virus de Arteritis Vírica Equina mediante ELISA y confirmación de dudosos mediante Seroneutralización + Detección de anticuerpos frente a Piroplasmosis Equina mediante ELISA de competición.
Análisis informativo para exportación a México.
@


| ● | Serología: Arteritis Vírica Equina (ELISA +/ SN) + Piroplasmosis Equina (cELISA) |
Referencia: A731
Serología: Arteritis Vírica Equina (ELISA +/ SN) + Piroplasmosis Equina (cELISA) + Anemia Infecciosa Equina (Test de Coggins)
Detección de anticuerpos frente al virus de Arteritis Vírica Equina mediante ELISA y confirmación de dudosos mediante Seroneutralización + Detección de anticuerpos frente a Piroplasmosis Equina mediante ELISA de competición + Detección de anticuerpos frente al virus de Anemia Infecciosa Equina mediante Test de Coggins.
Análisis informativo para exportación a Cabo Verde, Chile, Colombia, Ecuador.
@


| ● | Serología: Arteritis Vírica Equina (ELISA +/ SN) + Piroplasmosis Equina (cELISA) + Anemia Infecciosa Equina (Test de Coggins) |
Referencia: A736
Serología: Brucella (Rosa de Bengala) + Anemia Infecciosa Equina (Test de Coggins)
Detección de anticuerpos frente a Brucella spp. mediante Rosa de Bengala + Detección de anticuerpos frente al virus de Anemia Infecciosa Equina mediante Test de Coggins.
Análisis informativo para exportación a Nicaragua.
@


| ● | Serología: Brucella (Rosa de Bengala) + Anemia Infecciosa Equina (Test de Coggins) |
Referencia: A446
Antibiograma por difusión en agar
Antibiograma por difusión en agar basado en el método normalizado CLSI
| ● | Antibiograma por difusión en agar |
Referencia: A748
Antibiograma por microdilución en caldo de Enterobacterias (confirmación de posible producción de betalactamasas y/o carbapenemasas)
Realización de un antibiograma por el método de microdilución en caldo a partir de un cultivo bacteriano de Enterobacterias según la norma ISO 20776-1:2019 para confirmación de la posible producción betalactamasas y/o carbapenemasas
ISO


| ● | Antibiograma por microdilución en caldo de Enterobacterias (confirmación de posible producción de betalactamasas y/o carbapenemasas) |
Referencia: A447
Antibiograma por microdilución en caldo de Enterobacterias, Staphylococcus spp., Enterococcus y Campylobacter spp.
Realización de un antibiograma por el método de microdilución en caldo a partir de un cultivo bacteriano (Enterobacterias, Staphylococcus spp., Enterococcus y Campylobacter spp.) según la norma ISO 20776-1:2019
ISO


| ● | Antibiograma por microdilución en caldo de Enterobacterias, Staphylococcus spp., Enterococcus y Campylobacter spp. |
Referencia: A513
Estudio de la efectividad de diferentes productos frente a organismos bacterianos aerobios mediante técnicas de microdilución.
Estudio de la efectividad de diferentes productos frente a organismos bacterianos aerobios mediante técnicas de microdilución. El coste dependerá del número de diluciones solicitadas.
| ● | Estudio de la efectividad de diferentes productos frente a organismos bacterianos aerobios mediante técnicas de microdilución. |
Referencia: A515
Estudio de la efectividad de diferentes productos frente a organismos bacterianos anaerobios mediante técnicas de macrodilución.
Estudio de la efectividad de diferentes productos frente a organismos bacterianos anaerobios mediante técnicas de macrodilución. El coste dependerá del número de diluciones solicitadas.
| ● | Estudio de la efectividad de diferentes productos frente a organismos bacterianos anaerobios mediante técnicas de macrodilución. |
Referencia: A516
Estudio de la efectividad de diferentes productos frente a organismos bacterianos anaerobios mediante técnicas de microdilución.
Estudio de la efectividad de diferentes productos frente a organismos bacterianos anaerobios mediante técnicas de microdilución. El coste dependerá del número de diluciones solicitadas.
| ● | Estudio de la efectividad de diferentes productos frente a organismos bacterianos anaerobios mediante técnicas de microdilución. |
Referencia: A512
Evaluación de la efectividad de diferentes productos frente a organismos bacterianos aerobios mediante técnicas de macrodilución.
Evaluación de la efectividad de diferentes productos frente a organismos bacterianos aerobios mediante técnicas de macrodilución. El coste de los análisis dependerá del número de diluciones solicitadas
| ● | Evaluación de la efectividad de diferentes productos frente a organismos bacterianos aerobios mediante técnicas de macrodilución. |
Referencia: A586
Análisis coprológico en équidos
Contaje de huevos de parásitos en heces mediante técnica de flotación (McMaster Modificado)
| ● | Análisis coprológico en équidos |
Referencia: A583
Análisis microscópico de frotis sanguíneo en équidos (observación de piroplasmas en eritrocitos)
Detección de Babesia caballi y Theileria equi mediante observación directa en frotis sanguíneo. Certificado sanitario previo a exportación a Guatemala, Nicaragua.
| ● | Análisis microscópico de frotis sanguíneo en équidos (observación de piroplasmas en eritrocitos) |
Referencia: A562
Análisis parasitológico en heces de parásitos gastrointestinales
Análisis parasitológico en heces de parásitos gastrointestinales utilizando el método adecuado según el tipo de especie animal
| ● | Análisis parasitológico en heces de parásitos gastrointestinales |
Referencia: A574
Confirmación de aislados de Escherichia coli
Identificación de Escherichia coli mediante PCR tradicional
| ● | Confirmación de aislados de Escherichia coli |
Referencia: A576
Confirmación de aislados de Escherichia coli O157:H7
Identificación de Escherichia coli O157:H7 mediante PCR convencional
| ● | Confirmación de aislados de Escherichia coli O157:H7 |
Referencia: A577
Confirmación de Escherichia coli verotoxigénico
Identificación de aislados de Escherichia coli verotoxigénico mediante PCR convencional
| ● | Confirmación de Escherichia coli verotoxigénico |
Referencia: A593
Detección de ADN de Anaplasma phagocytophilum en muestras de équidos mediante PCR a tiempo real
Detección de ADN de Anaplasma phagocytophilum (erlichiosis equina) en muestras de sangre completa de équidos mediante PCR a tiempo real
| ● | Detección de ADN de Anaplasma phagocytophilum en muestras de équidos mediante PCR a tiempo real |
Referencia: A590
Detección de ADN de Borrelia spp. en équidos mediante PCR a tiempo real
Detección de ADN de Borrelia spp. en muestras de tejido nervioso o piel de équidos mediante PCR a tiempo real
| ● | Detección de ADN de Borrelia spp. en équidos mediante PCR a tiempo real |
Referencia: A604
Detección de ADN de Herpesvirus equino tipo 1 (HVE-1) y tipo 4 (HVE-4) en équidos (Rinoneumonitis equina) mediante PCR cuantitativa a tiempo real
Detección de ADN de Herpesvirus equino tipo 1 y tipo 4 (HVE-1 y HVE-4) en muestras de Hisopo / Tejido / Sangre completa Heparina 30 ml de équidos mediante PCR cuantitativa a tiempo real
@


| ● | Detección de ADN de Herpesvirus equino tipo 1 (HVE-1) y tipo 4 (HVE-4) en équidos (Rinoneumonitis equina) mediante PCR cuantitativa a tiempo real |
Referencia: A594
Detección de ADN de Herpesvirus equino tipo 2 (HVE-2) en équidos mediante PCR a tiempo real
Detección de ADN de Herpesvirus equino tipo 2 (HVE-2) en muestras de hisopo nasal u ocular de équidos mediante PCR a tiempo real
| ● | Detección de ADN de Herpesvirus equino tipo 2 (HVE-2) en équidos mediante PCR a tiempo real |
Referencia: A596
Detección de ADN de Herpesvirus equino tipo 5 (HVE-5) en équidos mediante PCR a tiempo real
Detección de ADN de Herpesvirus equino tipo 5 (HVE-5) en muestras de hisopo nasal u ocular de équidos mediante PCR a tiempo real
| ● | Detección de ADN de Herpesvirus equino tipo 5 (HVE-5) en équidos mediante PCR a tiempo real |
Referencia: A597
Detección de ADN de Leptospira spp. en équidos mediante PCR a tiempo real
Detección de ADN de Leptospira spp. en muestras de hisopo, orina o tejidos de équidos mediante PCR a tiempo real
| ● | Detección de ADN de Leptospira spp. en équidos mediante PCR a tiempo real |
Referencia: A603
Detección de ADN de Rhodococcus equi en équidos mediante PCR a tiempo real
Detección de ADN de Rhodococcus equi en muestras de hisopo, líquido o tejidos de équidos mediante PCR a tiempo real
| ● | Detección de ADN de Rhodococcus equi en équidos mediante PCR a tiempo real |
Referencia: A601
Detección de ADN de Streptococcus equi subsp. equi (Papera equina) en équidos mediante PCR a tiempo real
Detección de ADN de Streptococcus equi subsp. equi (Papera equina) en muestras de hisopo nasofaríngeo, lavado de bolsas guturales o aspirado/hisopo de ganglio linfático de équidos mediante PCR a tiempo real
@


| ● | Detección de ADN de Streptococcus equi subsp. equi (Papera equina) en équidos mediante PCR a tiempo real |
Referencia: A600
Detección de ADN de Taylorella equigenitalis (Metritis Contagiosa Equina) mediante PCR a tiempo real
Detección de ADN de Taylorella equigenitalis (Metritis Contagiosa Equina) en hisopos genitales de équidos mediante PCR a tiempo real
@


| ● | Detección de ADN de Taylorella equigenitalis (Metritis Contagiosa Equina) mediante PCR a tiempo real |
Referencia: A602
Detección de ADN de Theileria equi y Babesia caballi (Piroplasmosis equina) mediante PCR a tiempo real cuantitativa
Detección de ADN de Theileria equi y Babesia caballi (Piroplasmosis equina) en muestras de sangre completa de équidos mediante PCR a tiempo real cuantitativa
@


| ● | Detección de ADN de Theileria equi y Babesia caballi (Piroplasmosis equina) mediante PCR a tiempo real cuantitativa |
Referencia: A690
Detección de Alphavirus de salmónidos mediante RT-PCR en tiempo real
Detección de Sleeping disease virus (SDV)
| ● | Detección de Alphavirus de salmónidos mediante RT-PCR en tiempo real |
Referencia: A589
Detección de ARN de Bornavirus equino en équidos mediante PCR a tiempo real
Prueba para detección de ARN de Bornavirus equino en muestras de líquido cefalorraquídeo o tejido nervioso de équidos mediante RT-PCR a tiempo real
| ● | Detección de ARN de Bornavirus equino en équidos mediante PCR a tiempo real |
Referencia: A605
Detección de ARN de virus de Arteritis Vírica Equina mediante PCR a tiempo real
Prueba para la detección de ARN de virus de Arteritis Vírica Equina en muestras de hisopo, semen o tejidos de aborto de équidos mediante PCR a tiempo real
@


| ● | Detección de ARN de virus de Arteritis Vírica Equina mediante PCR a tiempo real |
Referencia: A607
Detección de ARN de virus de Influenza equina mediante RT-PCR a tiempo real en équidos residentes en la Comunidad de Madrid
Detección de ARN de virus de Influenza equina mediante RT-PCR a tiempo real en muestras de hisopo nasal/nasofaríngeo.
@


| ● | Detección de ARN de virus de Influenza equina mediante RT-PCR a tiempo real en équidos residentes en la Comunidad de Madrid |
Referencia: A606
Detección de ARN de West Nile Virus en équidos mediante PCR a tiempo real
Detección de ARN de West Nile Virus en muestras de sangre completa en EDTA, líquido cefalorraquídeo o tejido nervioso de équidos mediante RT-PCR a tiempo real
| ● | Detección de ARN de West Nile Virus en équidos mediante PCR a tiempo real |
Referencia: A689
Detección de Betanodavirus mediante RT-PCR en tiempo real
Detección de betanodavirus (ERV) mediante PCR en tiempo real.
| ● | Detección de Betanodavirus mediante RT-PCR en tiempo real |
Referencia: A691
Detección de Borrelia spp mediante PCR real time
Detección de la enfermedad de Lyme mediante PCR RT
| ● | Detección de Borrelia spp mediante PCR real time |
Referencia: A687
Detección de Brucella spp mediante PCR en tiempo real.
Detección de Brucella spp PCR en tiempo real
| ● | Detección de Brucella spp mediante PCR en tiempo real. |
Referencia: A553
Detección de Chlamydia psittaci mediante PCR en tiempo real
Detección de Chlamydia psittaci mediante PCR en tiempo real
| ● | Detección de Chlamydia psittaci mediante PCR en tiempo real |
Referencia: A688
Detección de Coxiella burnetii mediante PCR en tiempo real.
Detección de C.burnetii mediante PCR en tiempo real.
| ● | Detección de Coxiella burnetii mediante PCR en tiempo real. |
Referencia: A495
Detección de factores de virulencia de Escherichia coli mediante técnicas moleculares.
Detección de 5 factores de virulencia de Escherichia coli mediante técnicas moleculares
| ● | Detección de factores de virulencia de Escherichia coli mediante técnicas moleculares. |
Referencia: A556
Detección de Francisella tularensis mediante PCR Convencional
Detección de Francisella tularensis mediante PCR Convencional
| ● | Detección de Francisella tularensis mediante PCR Convencional |
Referencia: A554
Detección de Giardia duodenalis mediante PCR en tiempo real
Detección de Giardia duodenalis mediante PCR en tiempo real
| ● | Detección de Giardia duodenalis mediante PCR en tiempo real |
Referencia: A559
Detección de Leishmania infantum mediante PCR en tiempo real
Detección de Leishmania infantum mediante PCR en tiempo real
| ● | Detección de Leishmania infantum mediante PCR en tiempo real |
Referencia: A697
Detección de microorganismos pertenecientes al complejo Mycobacterium tuberculosis por PCR a tiempo real
Detección e identificación de micobacterias pertenecientes al complejo Mycobacterium tuberculosis mediante la técnica de Reacción en Cadena de la Polimerasa (PCR) a tiempo real, usando como diana la secuencia de inserción IS6110.
ISO


| ● | Detección de microorganismos pertenecientes al complejo Mycobacterium tuberculosis por PCR a tiempo real |
Referencia: A557
Detección de Rickettsia spp. mediante PCR en tiempo real
Detección de Rickettsia spp. mediante PCR en tiempo real
| ● | Detección de Rickettsia spp. mediante PCR en tiempo real |
Referencia: A578
Detección de serogrupos de Escherichia coli verotoxigénico mediante qPCR
Detección de serogrupos de Escherichia coli verotoxigénico mediante qPCR (cualitativa)
| ● | Detección de serogrupos de Escherichia coli verotoxigénico mediante qPCR |
Referencia: A558
Detección de Toxoplasma gondii mediante PCR en tiempo real
Detección de Toxoplasma gondii mediante PCR en tiempo real
| ● | Detección de Toxoplasma gondii mediante PCR en tiempo real |
Referencia: A561
Detección del Virus de la Hepatitis E mediante RT-PCR en tiempo real
Detección del Virus de la Hepatitis E mediante PCR en tiempo real
| ● | Detección del Virus de la Hepatitis E mediante RT-PCR en tiempo real |
Referencia: A544
Detección del virus de la Influenza tipo A mediante RT-PCR en tiempo real
Detección del virus de la Influenza tipo A mediante PCR en tiempo real
| ● | Detección del virus de la Influenza tipo A mediante RT-PCR en tiempo real |
Referencia: A569
Detección del virus de la necrosis pancreática infecciosa (IPN) mediante RT-PCR en tiempo real
Detección del virus de la necrosis pancreática infecciosa (IPN) mediante RT-PCR en tiempo real
| ● | Detección del virus de la necrosis pancreática infecciosa (IPN) mediante RT-PCR en tiempo real |
Referencia: A679
Detección del virus de la Peste Equina Africana (PEA) mediante PCR en tiempo real
Detección de Virus de la Peste Equina Africana mediante qPCR.
| ● | Detección del virus de la Peste Equina Africana (PEA) mediante PCR en tiempo real |
Referencia: A678
Detección del virus de la Peste Porcina Africana (PPA) mediante PCR en tiempo real.
Detección del virus de la Peste Porcina Africana (PPA) mediante PCR en tiempo real.
ISO


| ● | Detección del virus de la Peste Porcina Africana (PPA) mediante PCR en tiempo real. |
Referencia: A570
Detección del virus de la septicemia hemorrágica viral (VHSV) mediante RT-PCR en tiempo real
Detección del virus de la septicemia hemorrágica viral (VHSV) mediante RT-PCR en tiempo real
| ● | Detección del virus de la septicemia hemorrágica viral (VHSV) mediante RT-PCR en tiempo real |
Referencia: A546
Detección del virus de Newcastle mediante RT-PCR en tiempo real
Se realizarán dos PCRs: Wise et al., 2004 y Kim et al., 2008
| ● | Detección del virus de Newcastle mediante RT-PCR en tiempo real |
Referencia: A552
Detección del virus de West Nile mediante RT-PCR en tiempo real
Detección del virus de West Nile
| ● | Detección del virus de West Nile mediante RT-PCR en tiempo real |
Referencia: A441
Detección directa de micobacterias a partir de muestras clínicas
Detección e identificación de micobacteriosis mediante extracción directa de muestras clínicas animales y ambientales
| ● | Detección directa de micobacterias a partir de muestras clínicas |
Referencia: A579
Detección Escherichia coli verotoxigénico mediante qPCR
Detección Escherichia coli verotoxigénico mediante qPCR (cualitativa)
| ● | Detección Escherichia coli verotoxigénico mediante qPCR |
Referencia: A682
Detección y cuantificación de Campylobacter coli/jejuni mediante qPCR
Detección y cuantificación de C. coli/jejuni mediante qPCR cuantitativa
| ● | Detección y cuantificación de Campylobacter coli/jejuni mediante qPCR |
Referencia: A430
Identificación de bacterias mediante MALDI Biotyper.
Este sistema permite la identificación y clasificación de microorganismos mediante la determinación de su perfil de masas (característico de la mayoría de géneros y especies) y comparación con los existentes en la base de datos. La base de datos la componen más de 6000 entradas aportadas por los laboratorios de las principales agencias, instituciones y centros de investigación relacionados con la microbiología. La base de datos es abierta y permite la creación e intercambio con otras bases de datos existentes.
@


| ● | Identificación de bacterias mediante MALDI Biotyper. |
Referencia: A464
Identificación de Campylobacter spp.
Identificación de Campylobacter spp. mediante PCR convencional
| ● | Identificación de Campylobacter spp. |
Referencia: A438
Identificación de micobacterias mediante secuenciación
Identificación de micobacterias mediante secuenciación
| ● | Identificación de micobacterias mediante secuenciación |
Referencia: A701
Identificación de microorganismos pertenecientes al complejo Mycobacterium avium por PCR
| ● | Identificación de microorganismos pertenecientes al complejo Mycobacterium avium por PCR |
Referencia: A463
Identificación de Yersinia spp.
Identificación de Yersinia spp. mediante pruebas bioquímicas
| ● | Identificación de Yersinia spp. |
Referencia: A531
Identificación mediante la secuenciación del gen que codifica para el 16S ARNr
Identificación bacteriana molecular mediante la secuenciación del gen que codifica para el 16S ARNr
| ● | Identificación mediante la secuenciación del gen que codifica para el 16S ARNr |
Referencia: A470
Identificación por PCR de aislados de Pasteurella multocida recuperados en muestras de distinto origen animal
Identificación por PCR de Pasteurella multocida en muestras de distinto origen animal
| ● | Identificación por PCR de aislados de Pasteurella multocida recuperados en muestras de distinto origen animal |
Referencia: A475
Identificación por PCR de aislados de Streptococcus suis recuperados en muestras de distinto origen animal
Identificación por PCR de aislados de Streptococcus suis recuperados en muestras de distinto origen animal.
| ● | Identificación por PCR de aislados de Streptococcus suis recuperados en muestras de distinto origen animal |
Referencia: A490
Identificación por PCR de la subespecie de Photobacterium damselae
Identificación por PCR de la subespecie de Photobacterium damselae.
| ● | Identificación por PCR de la subespecie de Photobacterium damselae |
Referencia: A743
Pre-exportación: Piroplasmosis equina (cELISA + qPCR)
Detección de anticuerpos frente a Theileria equi y Babesia caballi (piroplasmosis equina) en suero de équidos mediante ELISA de competición + Detección de ADN de Theileria equi y Babesia caballi (Piroplasmosis equina) en muestras de équidos mediante qPCR a tiempo real.
@


∞


| ● | Pre-exportación: Piroplasmosis equina (cELISA + qPCR) |
Referencia: A744
Pre-exportación: Piroplasmosis equina (cELISA + qPCR) + Anemia infecciosa equina (Test de Coggins) + Muermo (FC) + Durina (FC)
Detección de anticuerpos frente a Piroplasmosis Equina mediante ELISA de competición + Detección de ADN de Theileria equi y Babesia caballi (Piroplasmosis equina) en muestras de équidos mediante qPCR a tiempo real + Detección de anticuerpos frente al virus de Anemia Infecciosa Equina mediante Test de Coggins + Detección de anticuerpos frente a Burkholderia mallei (Muermo Equino) mediante Fijación de Complemento + Detección de anticuerpos frente a Trypanosoma equiperdum (Durina Equina) mediante Fijación de Complemento. Análisis informativo para exportación a EEUU.
@


∞


| ● | Pre-exportación: Piroplasmosis equina (cELISA + qPCR) + Anemia infecciosa equina (Test de Coggins) + Muermo (FC) + Durina (FC) |
Referencia: A745
Reproductores: Taylorella equigenitalis (Metritis Contagiosa Equina) mediante PCR a tiempo real + Arteritis Vírica Equina (ELISA +/ SN)
Detección de ADN de Taylorella equigenitalis (Metritis Contagiosa Equina) mediante PCR a tiempo real en hisopo genital de équidos + detección de anticuerpos frente a Arteritis Vírica Equina mediante ELISA y confirmación de dudosos mediante Seroneutralización.
@


∞


| ● | Reproductores: Taylorella equigenitalis (Metritis Contagiosa Equina) mediante PCR a tiempo real + Arteritis Vírica Equina (ELISA +/ SN) |
Referencia: A746
Reproductores: Taylorella equigenitalis (Metritis Contagiosa Equina) mediante PCR a tiempo real + Arteritis Vírica Equina (ELISA +/ SN) + Anemia Infecciosa Equina (Test de Coggins)
Detección de ADN de Taylorella equigenitalis (Metritis Contagiosa Equina) mediante PCR a tiempo real en hisopo genital de équidos + detección de anticuerpos frente a Arteritis Vírica Equina mediante ELISA y confirmación de dudosos mediante Seroneutralización + detección de anticuerpos frente a Anemia Infecciosa Equina mediante Test de Coggins.
@


∞


| ● | Reproductores: Taylorella equigenitalis (Metritis Contagiosa Equina) mediante PCR a tiempo real + Arteritis Vírica Equina (ELISA +/ SN) + Anemia Infecciosa Equina (Test de Coggins) |
Referencia: A628
Perfil completo équidos
Hemograma, Proteínas Totales, Urea, Creatinina, Bilirrubina Total, CPK, GGT, GOT, Fosfatasa Alcalina, LDH, Albúmina, Globulinas, A/G
| ● | Perfil completo équidos |
Referencia: A759
Estabulación básica cerdo (peso al final del estudio de 50kg) en box en ABSL-3
Estabulación de cerdo (peso al final del estudio de 50kg) en box en ABSL-3 (por animal y día), incluyendo uso de las instalaciones, manutención, limpieza y gestión de los residuos, y revisión diaria de los animales, con un protocolo de bioseguridad básico.
| ● | Estabulación básica cerdo (peso al final del estudio de 50kg) en box en ABSL-3 |
Referencia: A757
Estabulación ratón en cubeta en rack ventilado en ABSL-2
Estabulación de ratón en cubeta en rack ventilado en ABSL-2 (por animal y día), que incluye el uso de las instalaciones, la manutención, el cambio de cubetas y limpieza, y la revisión de los animales.
| ● | Estabulación ratón en cubeta en rack ventilado en ABSL-2 |
Referencia: A758
Estabulación ratón en cubeta en rack ventilado en ABSL-3
Estabulación de ratón en cubeta en rack ventilado en ABSL-3 (por animal y día), incluyendo el uso de las instalaciones, manutención, cambio de cubetas y limpieza, y revisión diaria de los animales.
| ● | Estabulación ratón en cubeta en rack ventilado en ABSL-3 |
Referencia: A436
Diferenciación histológica de Preparados y Productos Cárnicos
Valoración microscópica basada en el estudio de las características estructurales de la pieza cárnica, cuyo objeto es observar el grado de transformación de la fibra muscular. El análisis requiere técnicas de procesado de tejidos y tinción histológica para permitir el estudio por parte de dos observadores y la emisión de un informe individualizado a cada derivado cárnico.
@


| ● | Diferenciación histológica de Preparados y Productos Cárnicos |
Referencia: A742
Estudio histológico de carne de ave 3mm
Estudio que combina un análisis histológico para identificar y cuantificar los diferentes tipos de tejido (muscular, conjuntivo, epitelial, nervioso) y una evaluación de los diferentes estadios de la degeneración de Zenker por dos observadores independientes. Así se puede establecer los tejidos y el porcentaje de los mismos presente en una muestra y permite distinguir entre producto cárnico y preparado de carne. Sólo se aplica a carne de ave.
@


| ● | Estudio histológico de carne de ave 3mm |
Referencia: A741
Estudio semicuantitativo de un preparado de carne
Se trata de determinar los diferentes porcentajes de los componentes de un preparado de carne (tejido muscular, adiposo, conjuntivo, hueso, cartílago, entre otros) mediante el empleo de un analizador de imágenes tras el procesado rutinario en el laboratorio de histología.
@


| ● | Estudio semicuantitativo de un preparado de carne |
